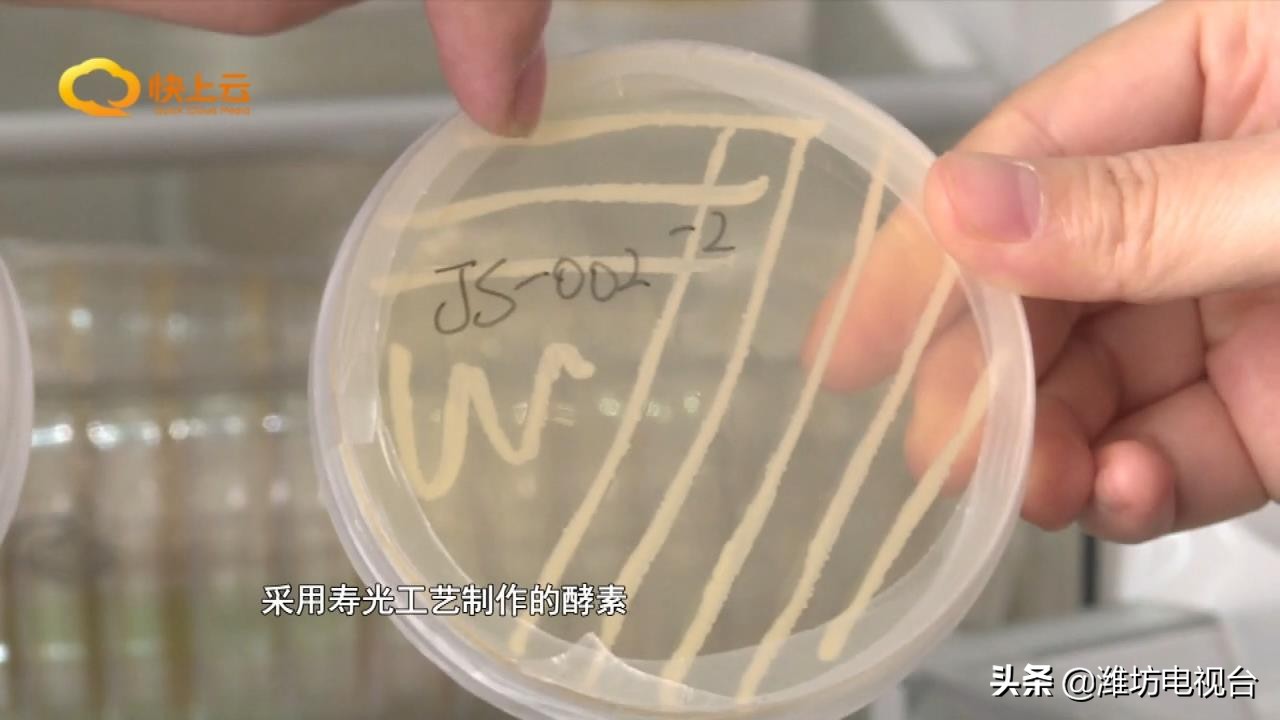
自制酵素真的这么神奇吗,环保酵素怎么改良土壤

寿光是我国传统设施农业的主要分布区,因长年连作,土壤板结等问题突出,为此,寿光市大力推广自制酵素示范行动,破解了土壤再生的密码。
黄家庄村菜农邵玉凤:(扔垃圾)麻烦呢,放哪里哪里不让,现在好了,使这些垃圾,叶子这些烂果全部都做成酵素,壮了地还减少了垃圾。

曾被视为农业垃圾的菜叶残果,如今在寿光正成为街头巷尾谈论的宝贝,说这话的邵玉凤连授粉的时候都不忘把坏菜叶收集起来做酵素。今年七月26号她定植的茄子,使用了首批自制的酵素,没想到效果出奇的好。
黄家庄村菜农邵玉凤:它这个亮度比往年的亮度都好,早上市,比平常的茄子高两毛钱,往年5天摘一遍,今年4天就摘着了。

今年四月,由寿光市政府专项资金支持的自制酵素示范行动在七个镇街展开。虽然有政策和资金扶持,但老百姓一开始并不买账。
东斟灌村菜农李志国:那么点点红糖,加上些菜叶子那样沤沤,就能管用?
尽管如此,抱着试试看态度的李志国还是在自家大棚里留出9垄彩椒做对比试验。使用两遍酵素水滴灌以后,对照的两组彩椒出现了明显的不同。


东斟灌村菜农李志国:同样是一车彩椒,你上市场上去过秤,使了酵素的和没使酵素的呢,能差80斤,我实验了4车。
中国农科院寿光蔬菜研发中心还专门针对10个村的50份自制酵素样本,做了采集分析,一个个培养皿里的有益菌丝,成为修复土壤,增加地力的关键。

中国农科院硕士研究生马腾飞:经实验分析,采用寿光工艺制作的酵素含有各类的芽孢杆菌和有益微生物菌群,能够改善根区微生物环境,促进根系发育,防治各类蔬菜土传病害,提高植株的免疫能力。
寿光市洛城街道农安办主任 李志萍:说明了我们农户自己制作的酵素绿色、环保、有推广基础,下一步,我们将在总结第一批制作发酵和使用经验的基础上,集中第二批酵素制作,力争街道1.8万多个蔬菜大棚都用上酵素,掀起一场“酵素革命”,切实提高蔬菜品质,打造洛城蔬菜品牌。

【WFTV战略合作:农业银行 特约播出】